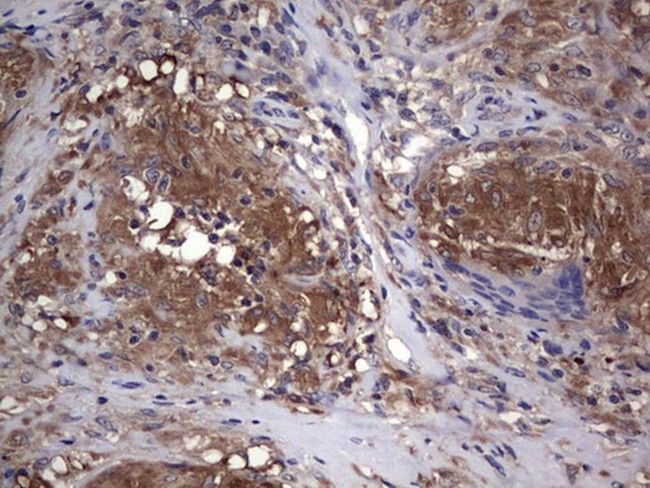
CSNK1E Antibody in Immunohistochemistry (Paraffin) (IHC (P))

Search
OriGene
CSNK1E Monoclonal Antibody (OTI5H10), TrueMAB™
{{$productOrderCtrl.translations['antibody.pdp.commerceCard.promotion.promotions']}}
{{$productOrderCtrl.translations['antibody.pdp.commerceCard.promotion.viewpromo']}}
{{$productOrderCtrl.translations['antibody.pdp.commerceCard.promotion.promocode']}}: {{promo.promoCode}} {{promo.promoTitle}} {{promo.promoDescription}}. {{$productOrderCtrl.translations['antibody.pdp.commerceCard.promotion.learnmore']}}
产品信息
TA803801
种属反应
宿主/亚型
分类
类型
克隆号
抗原
偶联物
形式
浓度
纯化类型
保存液
内含物
保存条件
运输条件
靶标信息
CSNK1E (CK1 epsilon) is a serine/threonine kinase implicated in a wide range of cellular functions, including vesicular trafficking, DNA damage repair, cell cycle progression, and cytokinesis. CSNK1E phosphorylate key regulatory proteins involved in the control of cell differentiation, proliferation, chromosome segregation, circadian rhythms, and metabolic pathways. CK1 family members share a highly conserved kinase domain but differ in their variable N-and C-terminal domains. Mammals have seven family members: alpha, beta, gamma1, gamma2, gamma3, delta and epsilon. CKIe positively regulates Akt possibly by inhibiting PP2A. CKIe play an important role in neurodegenerative diseases.
仅用于科研。不用于诊断过程。未经明确授权不得转售。
篇参考文献 (0)
生物信息学
蛋白别名: casein kinase 1; casein kinase 1, epsilon; Casein kinase I isoform epsilon; CK1e; CKI-epsilon; CKIe; MGC10398; OTTHUMP00000063258; OTTHUMP00000063263; RP1-5O6.1
基因别名: CKIepsilon; CSNK1E; HCKIE
UniProt ID: (Human) P49674
Entrez Gene ID: (Human) 1454